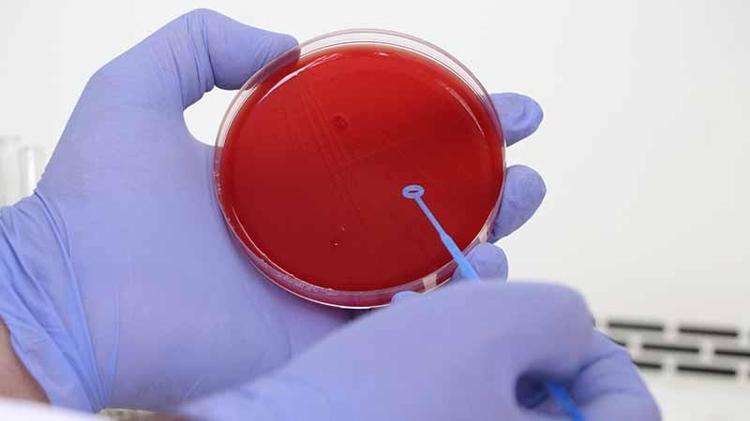

Türkiye'nin biyolojik kültür koleksiyonu
Sağlık Bakanlığı Halk Sağlığı Genel Müdürlüğü bünyesindeki Refik Saydam Ulusal Tip Kültür Koleksiyonu Laboratuvarı'nda 1371 adet bakteri suşu (patolojik kaynak), 77 adet küf ve mantar suşu, 2 parazit suşu bulunuyor. Türkiye’nin biyolojik hafızası niteliğindeki laboratuvarda, aşı ve tanı kiti çalışmaları başta olmak üzere bilimsel araştırmalara destek sağlanıyor.
Refik Saydam Ulusal Tip Kültür Koleksiyonu Laboratuvarı, Türkiye’de ilk ve en eski suş koleksiyonu olarak 1954 yılında kuruldu. Laboratuvarda 1371 adet bakteri suşu, 77 adet küf ve mantar suşu, 2 adet parazit suşu bulunuyor. Bu suşlar; üretim amaçlı kullanılmak üzere endüstriye, bilimsel araştırma ve çalışmalara, aşı çalışmalarına, Covid 19 tanı kiti üretimi başta olmak üzere pek çok alana standart mikroorganizma temin ederek stratejik destek sağlıyor. Türkiye’de varlığı bilinen 10 adet kültür koleksiyonundan aktif olarak çalışan tek koleksiyon Refik Saydam Ulusal Tip Kültür Koleksiyonu’nda, 1964 yılında İstanbul'da boğmaca hastalığı geçiren 6 yaşındaki 'Nursel' isimli çocuktan alınan 'şuş' da bulunuyor. Ülkedeki biyolojik çeşitliliğin gelecek nesillere aktarılması sağlanan koleksiyon bünyesinde son olarak covid 19, difteri, boğmaca, tetanos gibi hastalıkların aşıları ve test kitleri için de suş desteği sağlandı.

'BİYOLOJİK ÇEŞİTLİLİĞİN KORUNMASINA HİZMET EDİYOR'
Refik Saydam Ulusal Tip Kültür Koleksiyonu Laboratuvar Sorumlusu Uzman Doktor Demet Özyanar Yumuşak, mikroorganizmaların otantik şekilde canlılığını koruması, değişikliğe uğramadan saklanması ve sonraki nesillere aktarılmasının çok değerli olduğunu belirterek, "Kültür koleksiyonları buna hizmet etmektedir. Kültür koleksiyonumuzda şu anda 1371 adet bakteri, 77 adet küf ve mantar suşu, 2 adet ise parazit suşumuz mevcuttur. Burada bulunan mikroorganizmalarımız araştırmacılarımıza, üretim için endüstriye suş sağlamaktadır. Tabii ki belli prosedürler karşılığında suş verilmektedir. Kültür koleksiyonları, mikroorganizmaların hiçbir değişikliğe uğramadan, canlılığını kaybetmeden, otantik şekilde saklandığı merkezlerdir. 1992 yılında biyoçeşitlilik çerçevesiyle biyogen kaynaklarının kaybolmaması için kurulan bu kültür koleksiyonları da biyolojik çeşitliliğin korunmasına büyük hizmet etmektedir" diye konuştu.
'TÜRKİYE'DE BU KOLEKSİYONUN BENZERİ YOK'
Mikroorganizmaların bakteriler, virüsler, mantarlar, protozoalar, hücre dizileri olduğunu söyleyen doktor Özyanar Yumuşak, "Dünyadaki ilk kültür koleksiyonu 1890 yılında Çekya Cumhuriyeti'nde kurulmuştur. Daha sonra büyük İspanya gribi dünyayı etkiledikten sonra 1920 yılında ilk koleksiyon İngiltere'de kurulmuştur. Sonrasında 1925 yılında Amerika'da koleksiyon kurulmuştur. Türkiye'de ise Hıfzıssıhha Merkez Başkanlığı bünyesinde 1951 yılında kurulmasına karar verilmiş, 1954 yılında da 'Diagnostik Servis' adı altında kurulmuştur. Daha sonra bunun adı 'Suş Koleksiyonu Laboratuvarı' olarak değişmiştir. 2001 yılında ise bu laboratuvarın adı 'Refik Saydam Ulusal Tip Kültür Koleksiyonu' adını almıştır.

Suş demek patojen kaynak demek. Yani bakteri bir suştur, bir virüs suştur. Suşlar otantik, canlı, özellikleri tam olarak net belirlenmiş mikroorganizmalardır. Bunlar bakteri, mantar, küf, virüs olabilir. Koleksiyon demek ise insan ve hayvan için patojen, hastalık etkenlerini bulunduran koleksiyon demektir. Bunun dışında çevresel koleksiyonlar, gıda koleksiyonları ya da ziraat koleksiyonları gibi değişik alanların koleksiyonları da mevcuttur. Endüstri ve bilimsel araştırmalar için belirli kurallar dahilinde suşları verebiliyoruz. Suş kaydı yapıp, mikroorganizmalara patent veriyoruz. Türkiye'de bu koleksiyonun benzeri yok diyebiliriz. Türkiye'de aktif olarak çalışan tek suş laboratuvarı diyebiliriz burası için" dedi.

'NURSEL KIZIMIZIN SUŞU BURADA SAKLANMAKTA'
Laboratuvarın önemine dikkat çeken doktor Özyanar Yumuşak, "Hastalıklar için, stratejik önemi olan aşı suşlarımız vardır. Bu nedenle önemli bir koleksiyondur burası. Daha çok bilimsel araştırmalarda, ileri düzey tekniklerde, eğitimde, sağlıkta, gıda sektöründe, üretimde, endüstride kullanılmaktadır bu suşlar. Sağlık Bakanlığı'nın mottosu olan 'üreten, geliştiren, koruyan sağlık' için ileri düzey araştırmalara ihtiyaç vardır. Bu ileri düzey araştırmalar da standart suşlarla yapılmaktadır. Bu suşlara kaynak olan merkez burasıdır. Biz her bakteriyi alıp da koleksiyonumuza katmıyoruz. Mutlaka epidemiyolojik önemi olması, halk sağlığı için önemli olması ve standart olması bizim için referans kaynağı. Refik Saydam Ulusal Tip Kültür Koleksiyonu, biyolojik kaynak olarak ülkemizin hafıza koleksiyonudur. Örnek olarak verebilirsek, 1964 yılında boğmaca hastalığı geçiren 7 yaşındaki Nursel kızımızın suşu burada saklanmaktadır. Hala bu suşla ilgili aşı çalışmaları devam etmektedir. Yani hala o suş kullanılıyor aşı çalışmalarında" ifadelerini kullandı.

Kültür koleksiyonları çalışmalarıyla ile ilgili yeni yönetmelik de yazıldığını kaydeden doktor Özyanar Yumuşak, covid 19, difteri, boğmaca, tetanos gibi aşıları ve bu hastalıkların test kitleri için suş temin ettiklerini söyledi.








